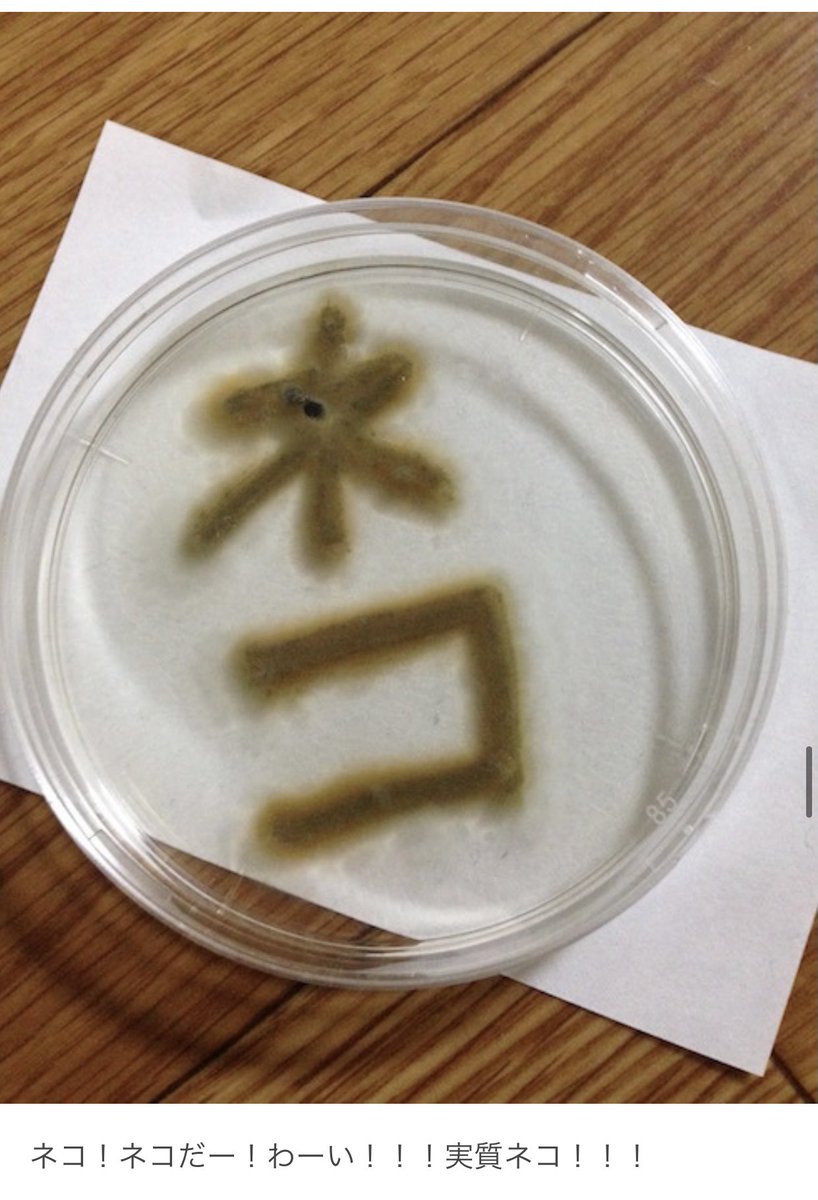
数年前野良猫から採取した菌を育てて楽しんでいた頃のブログをなんとなく読み返していたら結構面白かったので見てください

数年前野良猫から採取した菌を育てて楽しんでいた頃のブログをなんとなく読み返していたら結構面白かったので見てください。
ツイートに対するネットの反応
自分の猫のつめひっかかったとき
まあまあミミズ腫れなるから相当雑菌はいるんだろうな。
それか単純にねこアレルギー
こっちは好きなのになー
体が受け付けてない可能性あるのは切ないね
マホうさぎ(RDB:布団子守)@nao_capricerabi
動物のお医者さんで二階堂がやった卒論?がねこが持つ菌を調べるやつだったっけ……?(そしてねこが湧く泉としてペンギンのようなちょっと蛇口の締まりきらない水飲み場が…あれは札幌市内のどこかにひっそりとあるのだろうか…)
これみるとやはり猫や犬の肉球や爪にどれだけの菌がいるか解るな……。
引っかかれたり噛まれたりしたとき、しっかり洗おうな……。
猫ひっかき病だけでなく、雑菌入ってものすごく噛まれたところ腫れ上がったりするケースあるから……。


































